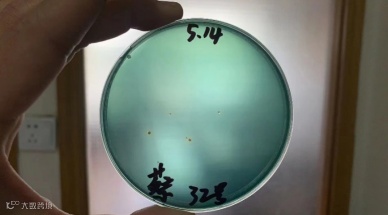
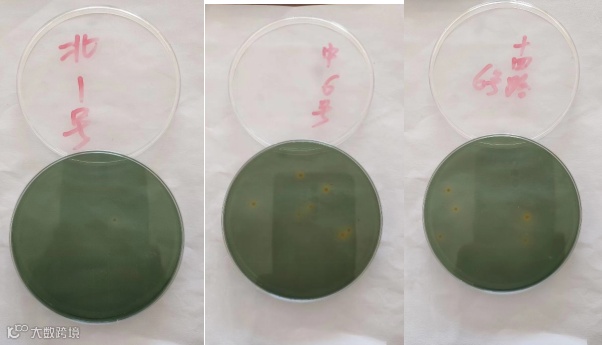
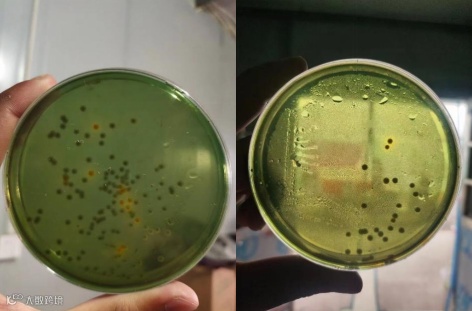

对虾弧菌防控方案
公认实用的控弧菌方案!4步搞定弧菌及偷死!
养好虾就是这么简单!
一 、选好苗:好虾苗,是养虾成功第一步!
(1)检测病毒,弧菌。
(2) 检测抗生素残留。
二、使用生物方式控制水体弧菌,减少消杀类产品的刺激。
(1)弧光(每7—10天使用一次,高效控制水体弧菌)
三、控制体内弧菌,提高虾的自身抗病能力
(1)弧光:拌料内服,控制体内弧菌
(2)虾青乳:提高虾体抗应激能力
(3)肠道好:增料,促进肠道肠黏膜生长,提高虾体免疫力。
四、 增加水体溶氧,正确地认识弧菌
(1)无论高位池还是土塘,改进增氧措施,提高溶氧,可明显减少病害,提高产量。
(2)弧菌来源广,繁殖快,很难被彻底消灭。
(3)防控弧菌是一个系统,采用科学的“养控”方案。
弧光控弧菌效果案例
实例一
地点:江苏如东环农,蔡老板
现象:2022年5月12日,水体黄弧菌超标,虾体内有少量绿弧菌
解决:当天下午使用弧光10g/3亩,30小时后检测,绿弧菌得到控制

实例二
地点:如东栟茶,李老板
使用情况:定期使用弧光,拌料防控弧菌。5月22日抽检,弧菌数量几乎为零,李老板非常满意。
实例三
地点:江苏盐城射阳,吴老板
现象:2022年5月14日,水体绿弧菌超标
解决:当天下午使用弧光10g/棚,5月16日再次检测,弧菌得到控制。
弧光使用方法
外泼用量:10g用1—2个棚,外塘3—5亩;用后30—48小时为弧菌最佳检测时间。
拌料用量:10g/包料;
使用频率:每周连拌3天,或外泼一次进行预防,同时配合虾青乳、丁酸梭菌等拌料用,效果更佳。
弧菌平板显色原理:TCBS培养基的显色指示剂是麝香草酚蓝,遇酸变黄,遇碱变蓝。
弧菌板的观察时间:以16—20小时观察最佳,时间过长,平板上的细菌进一步发酵蔗糖产生的有机酸(黄)转化成其他物质,会使原来显示黄色的菌落重新变为绿色,影响判断。


